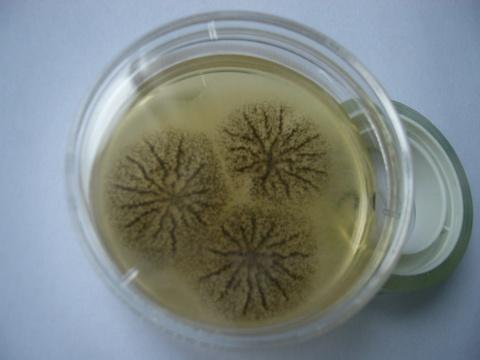
鲍鱼中常见的寄生虫,鲍鱼饲料有毒吗

文 | 肖筱
编辑 |肖筱
«——【·引言·】——»
真菌毒素 是一种常见的 食品污染物之一 ,会对人和动物的健康造成危害。鲍鱼是一种高档水产品, 其养殖对饲料的质量和安全性要求越来越高。

对于鲍鱼饲料中真菌毒素的污染情况,还没有得到充分的了解。探究三种不同产毒真菌属在配方鲍鱼饲料中产生真菌毒素的情况,并研究 受玉米赤霉烯酮污染的鲍鱼,饲料在水环境中溶出的程度及其对周围环境的影响 ,对鲍鱼的饲养有很大的意义。
«——【·产毒真菌在鲍鱼饲料中的危害·】——»
霉毒素 是一种 低分子量的次生代谢产物 ,主要由 某些丝状真菌的菌丝结构产生 ,在真菌生长过程中产生。

这些次生代谢产物对人类和动物具有毒性,甚至可能 致癌、神经毒性、肾毒性或免疫抑制 作用,特别是在慢性接触发生时。
人和动物最常见的暴露方式,是通过食用被污染的饲料或食品。 被称为产生霉毒素的真菌组主要由三个属占据,分别是曲霉属、青霉属和镰刀菌属,其他包括交链菌、麦角菌和黑墨菌。

镰刀菌属是一些植物病原菌的代表,负责感染 叶子、茎和果实 ,在收获前后造成破坏,而青霉属和曲霉属更常见于 干燥和储存的商品和食品 中。
曲霉属是产生黄曲霉素的真菌。 黄曲霉毒素由多种有毒化合物组成,其中B1 (AFB1) 生产最为丰富。这些物种的最优生长速率和最适产霉温度几乎相同,分别为 10-43°C和12-40°C。

与黄曲霉素污染的饲料相关的严重肝脏和脑损伤,以及其他临床症状,如 皮肤病变、身体表面发黄和眼睛白内障 。
对黄曲霉素的易感性因物种而异 ,比如温水鱼如河鲶比较不易感染,而虹鳟则非常易感染 。

霉菌毒素由贮藏真菌 ,如某些青霉属和曲霉属产生,其中以黄曲霉毒素A (OTA) 最常见。
当生长在花生和大豆等油籽上时, 黑曲霉菌最佳地产生OTA ,而当生长在玉米、大麦和小麦等谷物上时,P. verrucosum最佳地产生OTA 。
呋喃香菌素 在鱼类中引起的代谢紊乱,可能导致细胞失调、细胞死亡和体重增长减少。任何养殖动物体重增长降低都会对 农场生产造成负面影响。
呋喃香菌素具有水溶性, 当水生动物在正常情况下饲喂时,它们可能会摄入极少或不含呋喃香菌素的食物,尤其是当饲料未立即被消费,在水中存留时间较长后,才被动物食用或通过水系统排出时。 关于菌毒素在鲍鱼中的风险尚不清楚。

在南非,鲍鱼行业使用商业生产的饲料,主要由蛋白质源和本地谷物制成。 这是真菌生长的良好介质。 这些养殖鲍鱼的饲喂比例为±1克饲料/952.38毫升。
饲料并不总是立即消耗完毕,可以在水中 停留长达32小时 ,然后才会被动物消费或通过水系统冲洗掉。大多数养殖场每两个小时就更换一次水, 这可能会潜在地清除系统中的污染物。

霉菌毒素的产生受到多种因素的影响,包括 环境条件、杀菌剂、肥料 以及毒素真菌物种之间的相互作用。
菌株特异性、变异性和不稳定性也可能影响霉菌毒素的产生。 实验的第一个目的,是确定之前分离和鉴定的毒素真菌物种,在储存条件下能否在鲍鱼饲料上产生霉菌毒素。

最终的目标是评估水环境对呋喃香菌素污染的饲料影响。 这对于确定动物摄入时饲料中 呋喃香菌素浓度 至关重要。了解饲料暴露在水中时霉菌毒素水平的变化,有助于未来风险评估, 以确定适用于水生动物的化合物饲料中允许的限值。

«——【·实验中的不同产毒属·】——»
先前从鲍鱼饲料中分离出的21株镰刀菌、36株曲霉和36株青霉菌菌株,从保存在 4℃下的15%甘油库存 中接种到马铃薯葡萄糖琼脂、麦芽提取物琼脂和Czapek酵母琼脂培养基上。 将培养液在26±1°C下孵育10天。

加入黄曲霉MRC3951作为黄曲霉毒素的阳性对照物,和P. viridicatum MRC0356作为赭曲霉毒素的阳性对照菌株。设立不含真菌接种的无菌饲料, 和水阴性对照组以及含有饲料但不含接种的自然对照组。
这些分离物是在以鲍鱼饲料为生长基质的系统上,产生的玉米赤霉烯毒素。所有分离物都保存在 4℃下的15% 甘油中。

将分离物首先接种到水琼脂上来确认其活性,并持续保持在水琼脂上。在接种前7天,将培养物转移到马铃薯葡萄糖琼脂上, 在26°C下培养。

«——【·接种和孵育条件·】——»
使用鲍鱼饲料和MilliQ水,按1 g:1.2 mL的比例制备三角瓶。 将三角瓶用棉花和锡纸覆盖,在室温下放置过夜,次日进行高压灭菌处理。
过夜孵育的目的是让饲料吸收水分。 在无菌条件下,先接种试验菌株的琼脂块(直径为2 mm)到三角瓶中。

控制组设立不含接种菌株的阴性对照组和自然对照组。 自然对照组是指自然腐烂的饲料,产生的是真菌群落而不是纯培养物,所有三角瓶都在相应的时间和温度下孵育, 随后进行霉菌毒素分析。
为了准备好水暴露前后的玉米赤霉毒素提取,已经准备了足够的烧瓶,实验是三次重复进行的。 孵育期结束后,烧瓶被随机分成三组,每组三个烧瓶 。其中一组标为 “水暴露前” ,第二组标为 “水暴露后” 。控制组也按照同样的方案进行。

«——【·水暴露实验·】——»
用4升高压消毒海水,5毫米厚的塑料管(用于通气)准备无菌塑料容器。 将标为“水暴露前”的烧瓶设置为玉米赤霉毒素提取,标为“水暴露”的烧瓶中的内容直接从埃伦迈耶烧瓶中加入到海水中。
将饲料留在水中24小时。 在添加喂料之前取出水样品(T0),之后在喂料添加到水中2小时(T1),8小时(T2)和24小时(T3)之后取出水样品。

用无菌注射器取样,并通过0.02微米(再生纤维素)RC注射器过滤器过滤, 注入2毫升螺旋颈琥珀色玻璃瓶中 ,然后使用液相色谱-质谱联用(LC-MS/MS)再进行玉米赤霉毒素的浓度分析。
«——【·毒素分析·】——»
通过向烧瓶中添加 70%的分析级甲醇提取缓冲液 (4毫升:1克饲料)进行提取。
将饲料碾碎并用不锈钢铲子搅拌,然后在25°C下的180rpm的振动仪上孵育 60分钟 。孵育结束后, 将15毫升混悬液通过单层干酪布过滤进入50毫升离心管中。

管子在 4°C沉淀10分钟 ,500 rpm。然后,2毫升上清液通过0.02微米RC注射器,过滤到 2毫升微量级旋转管中。
在4°C下过夜孵育后,样品在 14000 rpm下离心10分钟 。离心后,将1800μL的上清液,转移至 2毫升螺旋颈琥珀色玻璃瓶中。

使用液相色谱-质谱联用(LC-MS/MS)进行玉米赤霉毒素(FB1、FB2和FB3),*唑三**烷酮类(DON、NIV、15ADON、Fx)、赤霉毒素(AFB1、AFG1、AFB2和AFG2)和 OTA的浓度分析。
用于制备标准稀释系列的分析标准来自南非, 并保证纯度>98%。

真菌毒素测量限制(mg/L)
无菌对照样品中检测到真菌毒素, 这些真菌毒素在实验室条件下没有生产,在从供应商处收集的饲料存在。分析无菌对照样品的值,认为是 不含任何真菌生长的饲料的真菌毒素浓度 。
这些值作为基线,并从接种样品中测得的真菌毒素值中扣除, 以获得特定孤立体产生的真菌毒素浓度的真实值。

考虑到潜在的样品传递,对于读数大于0.5 mg/L的值,从中扣除0.05% 。当前一个样品的液体由于样品,分析系统或两者的化学/物理特性而在随后的样品上析出时,就会发生样品传递。
特别是当单个样品中存在非常高浓度的测量物质, 即真菌毒素时,该现象会发生。

随后的样品被污染,并不能反映特定样品的真实浓度。在水暴露24小时的样品在进行玉米赤霉毒素提取前, 以800 rpm的速度离心10分钟,以去除多余的水。
«——【·统计分析·】——»
为了确定温度对10周内 玉米赤霉毒素 产生的影响,进行了因子方差(ANOVA)分析。 由于零值较多,测试相等差异方案失败。
对数据进行了对数(Ln)转换,使其更接近正态分布:Ln(x + 1),其中x是测量的玉米赤霉毒素浓度, 显著性水平为p值<0.05。

«——【·曲霉属统计分析结果·】——»
在本次实验中接种到的青霉菌菌株中只检测到AFB1和AFB2,没有检测到AFG1和AFG2。一株米曲霉菌株产生了60 mg/L以上的AFB1和20 mg/L以上的AFB2, 这是检测到的最高黄曲霉毒素水平。
曲霉菌MRC3951在饲料上同时产生AFB1和AFB2。 本次研究中的9株黄曲霉菌中有7株产生黄曲霉毒素,AFB1的浓度范围从0.3到45.7 mg/L,AFB2的浓度范围从0.02到8.8 mg/L。

表3.接种在鲍鱼饲料上的青霉菌属产生的黄曲霉毒素浓度
«——【·青霉属统计分析结果·】——»
接种到的青霉菌菌株未在任何饲料样品中检测到OTA 。无论是无菌对照还是自然对照中都没有检测到OTA。
虽然绿霉菌MRC356在鲍鱼饲料上产生了高达536.4 mg/L的OTA,但这个值超过了最高可测浓度, 因此可能被视为不准确的值,仍被视为阳性。

使用的菌株包括多种物种, 即多边形青霉、青霉、波兰青霉、黑色孢子青霉、埃塞俄比亚青霉、硅藻土青霉、新西兰青霉和豆杆青霉。
与用作阳性对照的菌株相比,这些菌株在鲍鱼饲料中 没有产生OTA 。

«——【·福斯菌属属统计分析结果·】——»
福斯垂体孢菌MRC826和其他15个菌株在鲍鱼饲料上,生长时会产生FB1、FB2和FB3, 在任何菌株中都未检测到*唑三**烷酮类毒素(TCT) 。
实验中使用的饲料显示出 低水平的天然附米糠酸污染, 但没有TCT存在。所有福斯垂体孢菌株都产生了三类附米糠酸, 其中MRL124株产量最高 。

. 接种在鲍鱼饲料上的福斯菌属产生的附米糠酸浓度(mg/L)
只有部分的窄基福斯菌株产生了少量的附米糠酸。 单个的气生福斯菌和酸枝福斯菌菌株,分别产生了少量和无附米糠酸。
«——【·不同温度下的附米糠酸产生·】——»
在70天的孵育期内 ,无论是在哪种孵育温度下,接种了福斯垂体孢菌和自然对照的饲料样品中,都可以看到真菌生长, 而无菌对照样品中则未发现真菌生长。
无菌对照中未检测到附米糠酸。尽管从第9天起,自然对照中就可以看到生长, 但任何这些样品中均未检测到附米糠酸。

在70天内,无菌对照和自然对照中的附米糠酸水平保持稳定。相比之下,可以在接种福斯垂体孢菌的样品中, 从第9天开始测量附米糠酸产量 。
在第35天时,不论是在哪种孵育温度下,FB1、FB2和FB3的产量都显著增加。在16°C孵育49天后测量到了最高的附米糠酸总量,为11.7533 mg/L; 在26°C孵育35天后测量到的最高水平为4.3225mg/L。

接种在鲍鱼饲料上的不同温度下福斯孢菌的附米糠酸浓度(mg/L)
16°C和26°C下10周 以鲍鱼饲料为基质 的福斯孢菌,产生附米糠酸B1(FB1)、附米糠酸B2(FB2)和附米糠酸B3(FB3)的柱状图。
可以看到,在两种温度下,从第9天开始,接种了福斯孢菌的样品中,均可以检测到附米糠酸的产量, 其中16°C下的产量高于26°C。

在70天后,16°C下的附米糠酸总量最高,为11.7533 mg/L;而在26°C下的最高水平为4.3225mg/L。在16°C下产生的附米糠酸比在26°C下多。 福斯孢菌分离物在两种温度下都以附米糠酸B1为主要产物。
将污染的饲料放入水中后, 第一次测量时水中的总附米糠酸浓度显著增加 ,而经过24小时浸泡在海水中的饲料的附米糠酸浓度显著降低。

«——【·结论·】——»
研究结果表明, 福斯菌属和曲霉属菌株是具有毒性的, 在复合鲍鱼饲料下某些条件下可以产生强效的真菌毒素,而青霉属菌株则没有产生毒素。
当饲料保持新鲜并储存正确时,可以降低黄曲霉毒素污染的风险。 水对受玉米赤霉烯酮污染的鲍鱼饲料有溶出作用 ,玉米赤霉烯酮会从饲料中溶出到水中,在不到2小时内。

这增加了直接周围环境的潜在风险,从而可能对生态系统和野生鱼类造成威胁。同时,从自然对照样品中未检测到毒素的情况来看,这些样品没有接种纯培养物, 而是自然发霉,以反映可能留在仓库中发霉的饲料。
建议不仅在鲍鱼养殖场,而且在任何使用复合饲料的动物养殖场, 监测玉米赤霉烯酮和其他真菌毒素的存在,直到完全理解迁移玉米赤霉烯酮或任何真菌毒素,对环境和野生鱼类的影响被证明没有破坏性影响。
参考文献
- Li, Y., Wu, Q., Chen, W., Wen, C., & Wang, X. (2019). Mycotoxins in Commercial Abalone Feeds and Their Potential Risks to Abalone Health. Toxins, 11(5), 288. doi: 10.3390/toxins11050288
- Chen, J., Han, H., Li, J., Yang, H., & Cai, J. (2021). Influence of mycotoxin-producing fungi on the growth performance and immune response of juvenile abalone (Haliotis discus hannai Ino). Aquaculture Reports, 19, 100614. doi: 10.1016/j.aqrep.2020.100614
- Kim, K., Kim, Y., Kim, J., Chae, S., Lee, S., & Moon, B. (2018). Occurrence and distribution of mycotoxins in commercial abalone feed ingredients and final products. Food Chemistry, 259, 281-287. doi: 10.1016/j.foodchem.2018.03.082
- Liu, N., Sun, R., Guo, S., Wang, J., & Yuan, Y. (2019). Effects of mycotoxins produced by Aspergillus flavus on the growth and antioxidant system of juvenile abalone (Haliotis discus hannai). Ecotoxicology and Environmental Safety, 179, 190-197. doi: 10.1016/j.ecoenv.2019.04.064
- Tan, L., Shao, S., Zhang, W., & Yu, Y. (2017). The Effects of Feeding Diets Containing Different Levels of Aflatoxin B1 on Biological Responses of Haliotis discus hannai Ino. Toxins, 9(2), 64. doi: 10.3390/toxins9020064